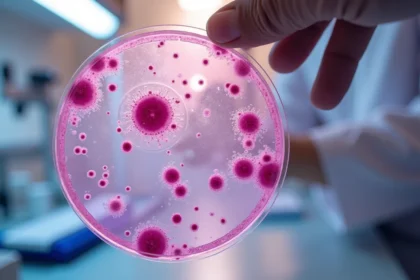
Bazofile – Normy, Rola i Znaczenie w Organizmie

Czy kiedykolwiek myślałeś o tym, ile może kosztować operacja nosa? W Katowicach ceny zaczynają się od 8610 zł, a w niektórych przypadkach mogą sięgać nawet 13 000 zł. Istotne jest, aby pamiętać, że na...
Koszt wykonania badania poziomu witaminy D3 w Polsce waha się od 71 zł do blisko 300 zł, co zależy od konkretnej placówki. Warto zatem porównać oferty różnych laboratoriów, aby znaleźć najlepszą cenę....
Czy zdajesz sobie sprawę, że optymalne spożycie witaminy C dla zdrowych dorosłych wynosi od 200 do 250 mg dziennie? Osoby, które palą, mogą mieć znacznie większe potrzeby — nawet do 1000 mg. Zrozumien...
Zastanawiasz się, jak najlepiej poradzić sobie z wirusem RSV? Istnieje wiele sposobów, które mogą pomóc w złagodzeniu objawów. Kluczowe jest, aby zadbać o układ oddechowy, co może znacząco przyspieszy...
Przed przystąpieniem do badania krwi ważne jest, abyś zachował 12-godzinną przerwę w jedzeniu i piciu. Taki post jest kluczowy, aby wyniki były miarodajne. Warto również pamiętać o kilku istotnych wsk...
Koszt in vitro to kluczowa sprawa dla par, które marzą o powiększeniu rodziny. Ceny tego typu procedur oscylują między 10 000 a 15 000 zł. Ostateczna kwota, jaką trzeba ponieść, zależy od różnych czyn...
Czy kiedykolwiek myślałeś o tym, ile nikotyny kryje się w papierosach i jaki ma to wpływ na Twoje zdrowie? Zawartość nikotyny w papierosie może wynosić od 5 do 20 mg, co jest znaczną ilością i może pr...
Dorosi ludzie najczęściej mają od 28 do 32 zębów stałych. Często jednak w okolicach 17. do 25. roku życia pojawiają się zęby mądrości, które stanowią dodatkowe uzębienie. To naprawdę fascynujący temat...
Bazofile to rodzaj białych krwinek, które, choć stanowią tylko 1% wszystkich tego typu komórek w naszym ciele, pełnią niezwykle ważną funkcję w systemie odpornościowym. Są aktywnie zaangażowane w reak...
Cykl miesiączkowy to fascynujący proces, który trwa od 21 do 35 dni, a najczęściej wynosi 28 dni. Zrozumienie, co wpływa na jego regularność, jest niezwykle istotne. Wiele czynników, takich jak: stres...